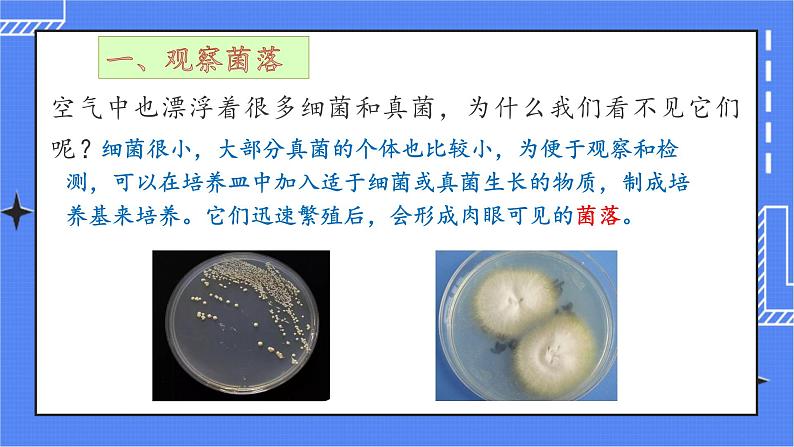
4.1 细菌和真菌的分布第5页
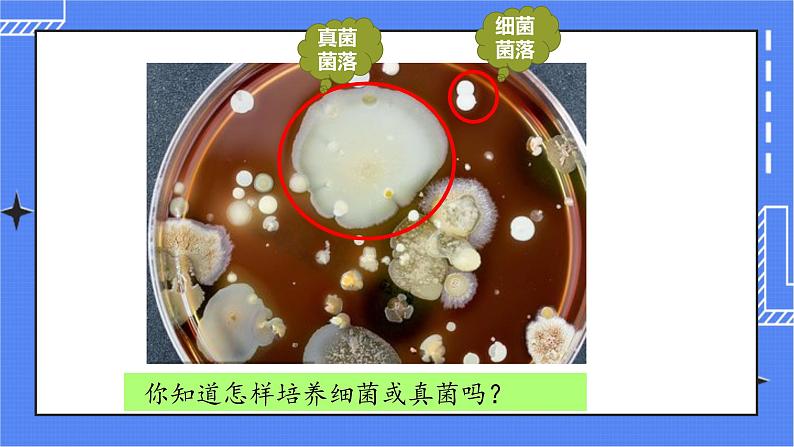
4.1 细菌和真菌的分布第7页

所属成套资源:人教版(新课标)生物八年级上学期PPT课件+视频整套
生物八年级上册第一节 细菌和真菌的分布优质课件ppt
展开
这是一份生物八年级上册第一节 细菌和真菌的分布优质课件ppt,文件包含41细菌和真菌的分布pptx、4班细菌真菌培养mp4、细菌和真菌的分布mp4等3份课件配套教学资源,其中PPT共19页, 欢迎下载使用。
第一节 细菌和真菌的分布
空气中也漂浮着很多细菌和真菌,为什么我们看不见它们呢?
细菌很小,大部分真菌的个体也比较小,为便于观察和检测,可以在培养皿中加入适于细菌或真菌生长的物质,制成培养基来培养。它们迅速繁殖后,会形成肉眼可见的菌落。
菌落:由一个细菌或真菌繁殖后形成的肉眼可见的集合体
任务:自主学习菌落的相关内容,完成下列表格
表面或光滑黏稠或粗糙干燥
绒毛状、絮状或蜘蛛网状
红、褐、绿、黑、黄等不同颜色
你知道怎样培养细菌或真菌吗?
阅读P67,总结细菌或真菌培养的一般步骤
1、配制含有营养物质的培养基
琼脂+营养物质=培养基
灭菌目的:杀灭培养基上原有的细菌和真菌的孢子冷却目的:防止高温杀死接种的细菌或真菌
把少量的细菌或真菌放到培养基上的过程。(此过程在无菌条件下进行)
把接种后的培养皿放在温度适宜的地方。
二、探究细菌和真菌的分布
提出问题:手上有没有细菌或真菌?作出假设:手上有细菌或真菌制定计划:取两套相同的装有牛肉汁培养基的培养皿,分别标号1和2;用无菌棉棒轻擦手心,在1号培养皿中轻轻涂抹,盖上盖。2号不做处理。将两培养皿放恒温箱中培养一段时间,观察结果。实验结果:实验结论:
提出问题:洗手前手上的细菌比洗手后多吗?作出假设:制定计划:实验结果:实验结论:
洗手前手上的细菌要比洗手后多
取三套相同的装有牛肉汁培养基的培养皿,分别标号1、2、3;洗手前用无菌棉棒轻擦手心,在1号培养皿中轻轻涂抹,盖上盖。洗手后,用无菌棉棒轻擦手心,在2号培养皿中轻轻涂抹,盖上盖,3号不处理。将3个培养皿放恒温箱中培养一段时间,观察结果。
提出问题:教室和操场的细菌一样多吗?作出假设:制定计划:实验结果:实验结论:
取三套相同的装有牛肉汁培养基的培养皿,分别标号1、2、3;将1号置于教室中,2号置于操场上,打开培养皿,暴露在空气中5-10分钟,再盖上,封好。3号不处理。将3个培养皿放恒温箱中培养一段时间,观察结果。
1.为什么培养用的培养皿和培养基,在接种前必须高温处理?为什么要用无菌棉棒?2.提示3相当于细菌、真菌一般培养方法中的哪一个步骤?3.通过各组的交流,你认为细菌和真菌的分布情况怎样? 4.什么环境条件下不可能有细菌和真菌?在这个探究中,不可能有细菌和真菌的情况存在吗?是什么情况?为什么?
高温处理,可以将培养皿上、培养基内的细菌和真菌杀死,就排除了实验外其他环境的污染。 实验中用无菌棉棒的目的同样是为了防止棉棒上的微生物污染培养基。
细菌和真菌分布广泛,几乎无处不在。但在不同环境中分布的多少不同
经过严格的高温灭菌的环境中不可能有细菌和真菌的存在,如对照组的一套培养皿,因为对照组的培养皿经高温灭菌后一直处在密封状态。
思考:细菌和真菌的生活必须具有哪些基本条件?
情景链接1、炎热的夏天,食物容易腐败,说明细菌真菌生存需要什么条件?2、受潮的粮食、衣物和皮鞋常常发霉长毛,而受潮的玻璃、石头、水泥墙不易发霉,说明细菌和真菌的生存需要什么条件?3、潮湿的种子比晒干的种子更容易发霉,说明细菌和真菌的生存需要什么条件?
细菌真菌的生活需要适宜的温度
细菌真菌的生活需要有机物
细菌真菌的生活需要水分
有的细菌还要求特定的条件,如无氧条件
1、观察菌落菌落:由一个细菌或真菌繁殖后形成的肉眼可见的集合体可从菌落的形态、大小和颜色大致区分细菌和真菌,以及它们的种类。培养细菌和真菌的一般方法:配制含有营养物质的培养基;高温灭菌、冷却;接种;恒温培养2、探究细菌和真菌的分布细菌和真菌分布广泛,生存需要一定的条件:水分、适宜的温度、有机物等
1、一个细菌或真菌繁殖的后代形成的肉眼可见的集合体被称为:( )A、菌群 B、菌斑 C、菌落 D、菌痕2、用无菌棉棒擦取手心,在培养基上轻轻涂抹,这个过程是:( )A、制作培养基 B、高温灭菌 C、接种 D、培养
3、小方在放久了的桔子上发现一团绿霉,她看到的是( )A、细菌 B、真菌 C、细菌菌落 D、真菌菌落4、通过学习了细菌真菌培养的一般方法后,小慧从培养流程中可以看出细菌真菌需要的基本条件是( ) A.水分B.有机物C.适宜温度D.以上三项
相关课件
这是一份初中生物人教版 (新课标)八年级上册第五单元 生物圈中的其他生物第四章 细菌和真菌第一节 细菌和真菌的分布教课ppt课件,共23页。PPT课件主要包含了树生木耳,想一想,课题一,观察总结,不同形态的菌落,细菌菌落,霉菌菌落,形态大小颜色,细菌的菌落,真菌的菌落等内容,欢迎下载使用。
这是一份初中生物人教版 (新课标)八年级上册第一节 细菌和真菌的分布多媒体教学ppt课件,共35页。PPT课件主要包含了腐烂的水果,自养细菌,厌氧菌等内容,欢迎下载使用。
这是一份人教版 (新课标)八年级上册第五单元 生物圈中的其他生物第四章 细菌和真菌第一节 细菌和真菌的分布教课ppt课件,共35页。PPT课件主要包含了腐烂的水果,自养细菌,厌氧菌等内容,欢迎下载使用。